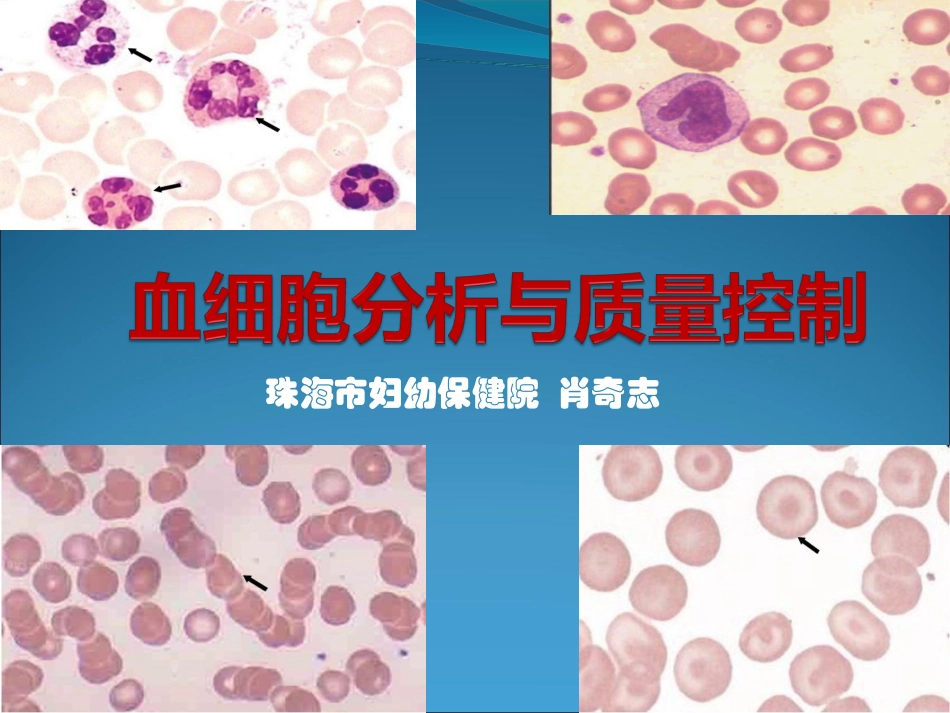
血细胞分析的质量控制_第2页

第十五届珠海市科技活动周珠海市医学会检验医学分会科技服务站斗门区侨立中医院检验科珠海市妇幼保健院肖奇志血细胞分析的定义对全血中的细胞、血红蛋白和相关参数进行定量分析或计算的过程
血细胞分析检测系统使用仪器配套试剂定期用配套校准物进行校准规范开展室内质控参加室间质评成绩优良操作人员经过培训检测系统的重要内涵检测系统的测定原理、试剂、仪器、校准品和质控品是最重要的条件,对其中任何一个进行更改或替换,都可以认为是检测系统的不一致
不同的检测系统可以得到不一样的结果,不配套的检测系统也会对检测结果带来明显影响
各仪器生产厂家都建立自己的标准检测系统以确保检验结果
仪器性能的评价新的仪器在投入使用前必须进行系统评价,仪器在大修(更换重要配件)后也应该进行性能重新评价
一般认为实验室在使用仪器前,必须在实验室的具体条件下,用实验方法证实检测系统的基本性能后,才可以将检测系统投入常规工作
仪器性能评价的基本内容稀释效应:稀释度与变量之间的线性范围越宽越好
稀释度应覆盖生理和常见病理范围
精密度:应包括批内和批间精密度和总精密度
应包括高、中、低三个浓度,覆盖生理和病理范围
携带污染率:对高值和低值的标本携带污染进行评价,保证交叉测量时的准确性
准确性:测定结果与真值之间的一致性
真值应采用参考方法或决定性方法获得
白细胞分类:显微镜分类法—200cells/片,2人分类计数
(国标WS/T246)血液分析仪的校准对分析设备的加样系统、检测系统、温控系统进行校准(适用时)
血液分析仪的校准应符合WS/T347-2011《血细胞分析的校准指南》的要求,包括:(a)应对每一台仪器进行校准;(b)应制定校准程序,内容包括校准物的来源、名称,校准方法和步骤,校准周期等;(c)应对不同吸样模式(自动、手动和预稀释模式)进行校准或比对;(d)可使用制造商提供的配套